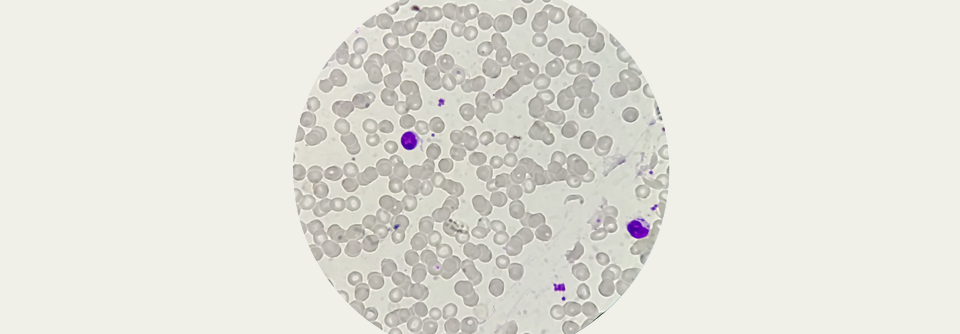

Mikrotubulibindender Wirkstoff Neutropenien an den Kragen
 Chemotherapie-Patienten müssen vor Neutropenien geschützt werden.
© iStock/mphillips007
Chemotherapie-Patienten müssen vor Neutropenien geschützt werden.
© iStock/mphillips007
Docetaxelbasierte Chemotherapien führen häufig zu einer schweren Neutropenie. Die Folge: Das Regime muss modifiziert werden, was sich negativ auf die Effektivität auswirken könnte. Leitlinien empfehlen die G-CSF Filgrastim und Pegfilgrastim als Standard-Prophylaxe, um solche Neutropenien möglichst zu verhindern. Ein Schwachpunkt der Präparate ist die relativ geringe Wirkung in der ersten Woche.
Kollegen um Prof. Dr. Douglas W. Blayney vom Stanford Cancer Institute verglichen nun in einer Phase-3-Studie Plinabulin – einen immunmodulierenden mikrotubulibindenden Stoff – mit Pegfilgrastim. Dazu schlossen sie 105 Patienten mit Brust-, Prostata- oder Lungenkrebs in die Untersuchung ein. Die…
Bitte geben Sie Ihren Benutzernamen und Ihr Passwort ein, um sich an der Website anzumelden.